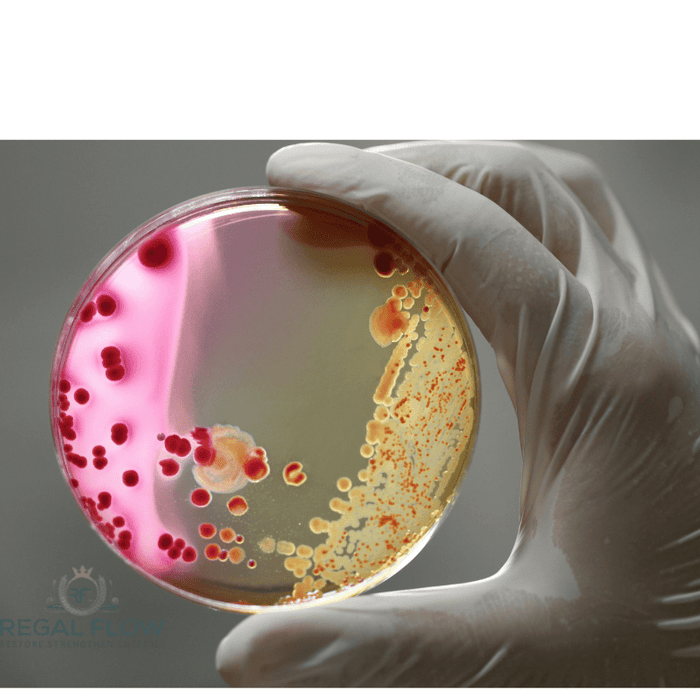
Bacteria being held in a hand

Expert Water & Home Care Guides | Tips, Reviews & Advice
-

-

-

What to Look for in a Whole House Water Filtration System
Read nowEssential Guide to Whole House Filters
-

What Are the Problems with Whole House Water Filtration Systems?
Read nowSolving Whole House Filter Issues
-

-

How Does Water Flow Through a Whole House Water Filter?
Read nowWater’s Journey Through Whole House Filters
-

-

-

-

What Are the Disadvantages of a Whole House Water Filter?
Read nowThe Downsides of Whole House Filters
-

How Much Should It Cost to Install a Whole House Water Filtration System?
Read nowWhole House Filter Cost Breakdown
-

Do I Need a Water Softener If I Have a Whole House Water Filter?
Read nowCleaner, Softer Water Explained
-

-

-

-

-

-

-

-

How Often Should You Replace Your Whole House Water Filter?
Read nowWhole House Filter Replacement Tips
-

-

-

-

-

-

-

-

Which Whole House Water Filter Removes the Most Contaminants?
Read nowMulti-Stage Whole House Filters
-

Should a Whole House Water Filter Be Before or After a Pressure Tank?
Read nowOptimal Filter and Tank Order
-

How to Install a Whole House Water Filter Outdoors: A Step-by-Step Guide
Read nowOutdoor Whole House Filter Guide
-

How to Install Express Water Whole House Filter: Step-by-Step Guide
Read nowStep-by-Step Express Water Setup
-

-

-

Where Should a Whole House Water Filter Go: Before or After the Water Heater?
Read nowFilter Placement Made Simple
-

-

Where Is the Best Place to Install a Whole House Water Filter?
Read nowBest Whole House Filter Placement
-

-

Whole-House Filtration System Installation: The Ultimate DIY Guide
Read nowInstall Whole House Filters Right
-

-

Where to Install a Whole House Water Filter in Your UK Home
Read nowBest Spot for Filter Installation
-

-

-

-

-

-

-

-

-

Can You Run Hot Water Through a Water Softener? A UK Guide
Read nowProtect Your Water Softener System
-

-

-

-

-

-

-

-

-

-

-

-

-

What is the Clack® DV Valve? A Simple Guide to a Clever Water System Hero
Read nowSmart Valve, Smooth Water Flow
-

-

-

Can You Use a RO System with a Water Softener? Here’s Why You’ll Want To
Read nowSoftened and Purified Water
-

-

Unlock Exceptional Coffee with Reverse Osmosis for Your Shop
Read nowBetter Coffee Starts With Better Water
-

-

-

-

Maintaining Your Commercial RO System: Best Practices and Tips
Read nowProven Tips for RO Maintenance
-

-

Optimising Coffee Shop Operations with RO Water Filtration
Read nowBoost Coffee Quality & Efficiency
-

Reverse Osmosis in Healthcare and Laboratories: Ensuring Purity and Safety
Read nowEnsuring Purity in Healthcare
-

Implementing RO Technology in Hospitality: Elevating Guest Experience
Read nowBoost Guest Satisfaction with RO
-

RO Systems in the Food & Beverage Industry: Enhancing Quality and Compliance
Read nowPurify Water, Elevate Flavour
-

Why Is Reverse Osmosis Expensive? Here's What You Need to Know
Read nowUnderstanding the Cost of RO Systems
-

-

-

-

-

-

-

-

Can Reverse Osmosis Water Dehydrate You? The Truth Uncovered
Read nowUnderstanding RO Water Hydration
-

-

-

Are Reverse Osmosis Systems Worth It? A Deep Dive into Clean Water Solutions
Read nowReverse Osmosis System Benefits
-

-

Are Reverse Osmosis Filters Universal? The Truth Behind the "One-Size-Fits-All" Myth
Read nowUnderstanding RO Filter Compatibility
-

-

How Long Does a Reverse Osmosis Tank Last? Lifespan, Signs & Care Tips
Read nowMaximising RO Tank Lifespan
-

-

Understanding Reverse Osmosis Water Hammer: Causes and Solutions
Read nowStop Banging in RO Systems
-

Reverse Osmosis vs Carbon Filter: Which Water Filtration System is Right for You?
Read nowComparing Water Filtration Systems
-

The Importance of Light Commercial Reverse Osmosis Systems for Your Business
Read nowEssential Water Filtration for Businesses
-

-

Industrial Reverse Osmosis Cost per Gallon: What UK Businesses Need to Know
Read nowCut costs with smart RO strategies
-

-

-

Commercial Water Filtration Systems: Ensuring Clean Water for Your UK Business
Read nowBest Water Filtration Systems
-

Can Reverse Osmosis Remove Bacteria? A Clear Answer for Safer Drinking Water
Read nowHow RO Keeps Water Safe
-

Reverse Osmosis Water Filter for Aquariums: A Guide to Cleaner, Healthier Tanks
Read nowClean Water, Healthy Fish
-

Tankless Reverse Osmosis Systems: A Smart, Space-Saving Solution for Clean Water
Read nowEfficient Water Purification Solution
-

The Ultimate Guide to Reverse Osmosis Countertop Systems
Read nowCompact, Efficient Water Filtration
-

-

The Ultimate Guide to Reverse Osmosis Water Lines: Installation, Maintenance, and Troubleshooting
Read nowReverse Osmosis Water Line Guide
-

Reverse Osmosis System Water Quality: Everything You Need to Know
Read nowEnsure Pure, Safe RO Water
-

Reverse Osmosis System Connections: A Complete Guide to Installation, Maintenance, and Performance
Read nowMaster Your RO System Connections
-

-

-

Reverse Osmosis Power Consumption: A Guide to Efficiency and Sustainability
Read nowOptimise RO System Efficiency
-

-

Reverse Osmosis vs. Carbon Filters for Well Water: Which is Best for Your Needs?
Read nowWell water filtration compared
-

Is Reverse Osmosis Water Good for Coffee? Exploring Water Quality for the Perfect Brew
Read nowThe Best Water for Coffee
-

How to Maintain Your Reverse Osmosis System for Longevity and Performance
Read nowEssential Tips for RO Maintenance
-

Does Reverse Osmosis Remove Viruses from Water? Understanding the Filtration Process
Read nowHow RO Fights Waterborne Viruses
-

-

Reverse Osmosis and Ozonation: A Powerful Pair for Water Purification
Read nowPowerful Water Treatment Solution
-

Reverse Osmosis in Chemistry: Unlocking the Science Behind Water Purification and More
Read nowThe Science Behind Reverse Osmosis
-

-

-

-

Is Reverse Osmosis Good for Well Water? Here's What You Need to Know
Read nowPurifying Well Water with RO
-

-

-

The Complete Guide to Reverse Osmosis Window Cleaning Equipment
Read nowYour Guide to Streak-Free Windows
-

Reverse Osmosis Window Cleaning: Achieving Spot-Free, Streak-Free Results
Read nowAchieve Streak-Free Windows Easily
-

How Reverse Osmosis Water Treatment Plants Work (and Why We Need Them)
Read nowClean Water, RO Style
-

Reverse Osmosis in Plants: The Secret to Cleaner, Happier Watering
Read nowPure Water, Healthier Plants
-

-

Reverse Osmosis vs Hydrogen Water: Which Should You Choose?
Read nowSmart Choices for Safer Sipping
-

-

Reverse Osmosis vs Deionised Water: What’s the Difference?
Read nowChoosing the Right Water Purifier
-

Reverse Osmosis vs Ultrafiltration: Which Water Filter Wins?
Read nowClear Choices for Cleaner Water
-

Reverse Osmosis and UV Water Filters: The Ultimate Guide for UK Homes
Read nowClean Water, Smart Filtration
-

Reverse Osmosis vs Ultrafiltration: Which One’s Best for Your Water?
Read nowChoosing the Right Water Filter
-

Reverse Osmosis Explained: Stages, Systems & How to Choose the Right RO Filter
Read nowClean Water, Stage by Stage
-

-

What Does Reverse Osmosis Remove? A Deep Dive into Water Filtration
Read nowUnderstanding RO Water Filtration
-

-

-

-

Reverse Osmosis vs Water Softeners: What’s Best for Your Home?
Read nowChoose Cleaner Water Smarter
-

-

Reverse Osmosis vs Bottled Water: The Clear Winner for UK Homes
Read nowChoosing Cleaner Water Options
-

Reverse Osmosis in Wastewater Treatment: A Practical Guide
Read nowTurning Wastewater into Resource
-

-

-

-

Benefits of Using a Countertop Water Dispenser in Your Home or Office
Read nowWater When You Want It
-

Countertop Water Dispenser: Installation & Maintenance Tips
Read nowSimple Steps for Dispenser Maintenance
-

Understanding Filter Pore Size: What It Means for Your Countertop Water
Read nowClear Water with Right Pore Size
-

Sediment Filtration: Protecting Your Countertop Water Dispenser
Read nowProtect Your Dispenser, Enjoy Clean Water
-

UV Purification: How Light Disinfects Your Countertop Water
Read nowLight-Powered Water Disinfection
-

Key Features to Look for in a Countertop Water Dispenser
Read nowWhy You Need a Countertop Dispenser
-

Countertop Water Dispensers: Which One Suits Your Needs?
Read nowChoosing the Right Water Dispenser
-

Understanding Countertop Water Dispensers: A Complete Overview
Read nowYour Countertop Hydration Made Easy
-

Water Dispenser vs. Water Filter: Which One Should You Choose?
Read nowChoosing the Right Water Solution
-

-

The Ultimate Guide to Countertop Water Dispenser Maintenance
Read nowCountertop Dispenser Care Guide
-

Should You Turn Off Your Countertop Water Dispenser at Night?
Read nowSaving Energy with Water Dispensers
-

-

The Ultimate Guide to Choosing a Countertop Water Dispenser
Read nowFind Your Ideal Water Dispenser
-

How to Choose the Right Countertop Water Dispenser for Your Home
Read nowChoosing Your Ideal Water Dispenser
-

Countertop vs. Freestanding Water Dispensers: Which One Wins?
Read nowChoosing the Best Water Dispenser
-

Understanding Filtration Systems in Countertop Water Dispensers
Read nowHow Countertop Water Filters Work
-

-

Do Countertop Water Filtration Systems Really Work? The Truth Revealed
Read nowThe Truth About Countertop Filters
-

Are Countertop Water Filters Worth It? A Cost & Benefit Breakdown
Read nowCost & Benefits of Water Filters
-

How Does a Countertop Water Filter Work? Explained Simply
Read nowClean Water, Straight from Your Countertop
-

Step-by-Step Guide to Installing a Countertop Water Dispenser
Read nowEffortless Countertop Water Dispenser Setup
-

Routine Maintenance Tips to Keep Your Water Dispenser Running Smoothly
Read nowExtend Your Water Dispenser’s Lifespan
-

-

How Often Should You Clean Your Countertop Water Dispenser?
Read nowEssential Water Dispenser Cleaning Guide
-

How Long Does a Countertop Water Filter Last? A Complete Guide
Read nowCountertop Water Filter Lifespan Explained
-

Countertop Water Dispenser Maintenance: Keep It Clean & Efficient
Read nowMaintain Your Dispenser Like a Pro
-

-

-

Best Countertop Water Dispenser Maintenance: Easy Cleaning Guide
Read nowSimple Water Dispenser Care Guide
-

Countertop Water Dispenser Troubleshooting: Fix Common Issues Fast
Read nowQuick Fixes for Dispenser Issues
-

How Countertop Water Dispensers Improve Drinking Water Quality
Read nowCleaner, Safer, and Better-Tasting Water
-

-

Stay Hydrated Effortlessly: The Benefits of Water Dispensers
Read nowEffortless Hydration with Water Dispensers
-

Alkaline Water Dispensers: Do They Really Offer Health Benefits?
Read nowAre Alkaline Water Dispensers Worth It?
-

-

-

-

-

-

The Health & Environmental Benefits of Countertop Water Dispensers
Read nowCleaner Water, Greener Living
-

-

-

How to Reduce Your Water Bills: Simple Tips for Big Savings
Read nowEasy Water-Saving Tips & Tricks
-

-

Do Water Dispensers Use a Lot of Electricity? A Cost Breakdown
Read nowWater Dispenser Energy & Costs
-

-

-

-

Well Water Woes? Find the Best Countertop Dispenser for Clean Water
Read nowChoosing the Best Water Dispenser
-

Best Countertop Water Dispensers for Hard Water: Top Picks & Tips
Read nowCombat Hard Water with Filtration
-

-

Activated Carbon Filtration: How It Works & What It Removes
Read nowHow Activated Carbon Purifies Water
-

-

Can a Plumber Fit a Water Softener? (The Answer: Yes, and Here's Why)
Read nowWhy Choose a Professional Plumber?
-

Can You Rinse Resin Down the Drain? The Hidden Dangers & Safe Disposal Methods
Read nowResin Disposal Risks & Solutions
-

The Easiest Way to Clean Resin Out of a Pipe – A Step-by-Step Guide
Read nowBest Methods for Resin Clean up
-

How to Flush Water Softener Resin Out of Pipes: A Step-by-Step Guide
Read nowRemove Resin from Pipes
-

Will Turning Off My Water Softener Cause Damage? The Essential Guide
Read nowDoes Switching Off Cause Issues?
-

-

-

-

-

What Water Softener Pellets Do I Need? Get the Answer Here
Read nowSoftener Pellets: Which One’s Best?
-

-

-

Maintaining Your Water Softener: Tips for Optimal Performance
Read nowKeep Your Softener Running Smoothly
-

-

-

-

-

-

Choosing the Right Water Softener: Does it Matter Which One You Buy?
Read nowChoosing the Best Water Softener
-

-

-

Do You Need a Separate Drinking Water Tap with a Water Softener?
Read nowSoftened Water: Tap or Not?
-

-

Salt-Based vs. Salt-Free Water Softeners: Which is Right for You?
Read nowComparing Water Softening Effectiveness
-

-

Common Myths About Water Softeners Debunked: The Truth You Need to Know
Read nowSeparating Fact from Fiction on Water Softeners
-

-

-

-

-

-

-

-

-

-

Water Softener vs Water Conditioner: Pros, Cons, and Which One You Need
Read nowCompare, Decide, and Improve Water
-

Water Softener vs Reverse Osmosis: How to Choose the Right System
Read nowFind the Right Filtration System
-

The Difference Between a Water Softener or Whole House Filtration
Read nowSoftening vs. Filtration: Key Differences
-

-

-

How to Convert Hard Water to Soft Water Naturally
Read nowReduce Limescale with these Natural Techniques
-

-

-

-

-

Understanding Hard Water: Causes, Effects, and Solutions
Read nowHow Hard Water Affects Your Home and Health